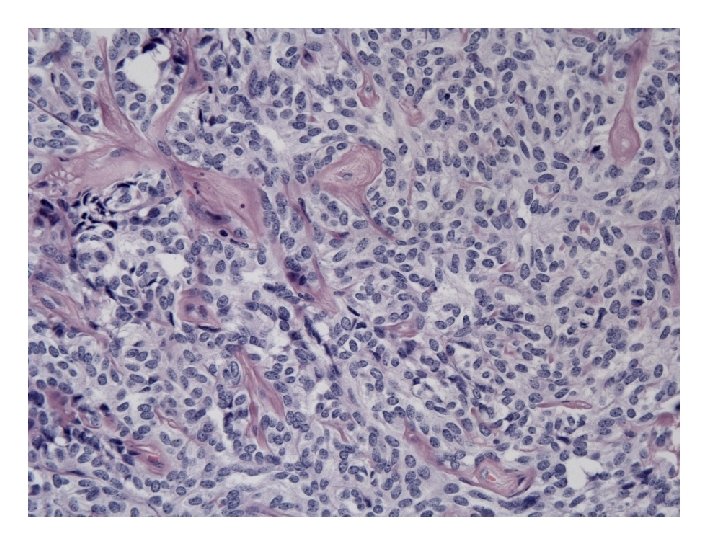
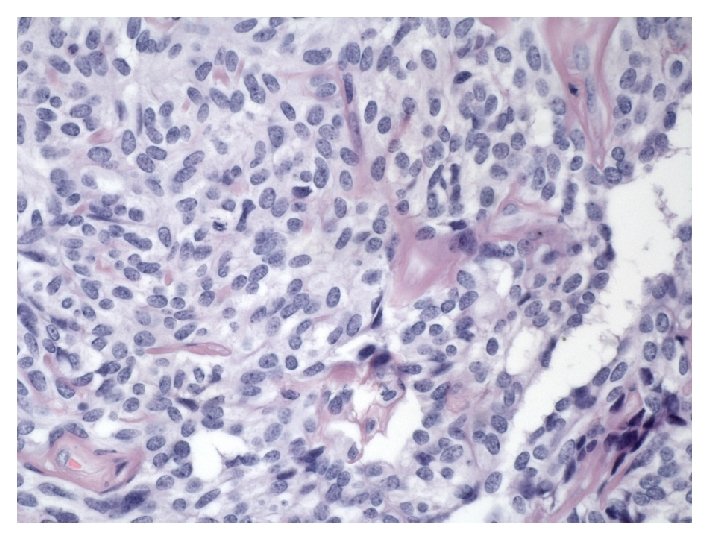

Histosminaire conjoint 27 mai 2009 Dre Katherine Grondin

- Slides: 48
Histoséminaire conjoint 27 mai 2009 Dre Katherine Grondin Dre Jocelyne Arseneau Pathology dept, RVH Mc. Gill University
48 y. o. woman Adnexal mass, 14 cm
Macroscopy • 14 x 11 x 10 cm mass • Encapsulated, bosselated, multinodular with solid cut surface
Tumors of the Ovary • • • Surface epithelial tumors Germ cell tumors Sex cord-stromal tumors Germ cell sex cord-stromal tumors Rare stuff Metastasis
Tumors of the Ovary • • • Surface epithelial tumors Germ cell tumors Sex cord-stromal tumors Germ cell sex cord-stromal tumors Rare stuff Metastasis
• Mixtures of growth patterns with solid and cystic components: Granulosa, adult-type?
• Mixtures of growth patterns with solid and cystic components: Granulosa, adult-type? - too much cytoplasm - no Call-Exner - no nuclear grooves
• Non-grooved nuclei and some foci looking somehow follicular: Granulosa, juvenile-type?
Granulosa, juvenile-type ? • 48 yo • No thickened layer of granulosa cells lining the « follicular spaces » Robboy’s 2009 • Chromatine is fine and evenly distributed (vs coarse chromatine, hyperchromatic nuclei in juvenile granulosa) • No mitoses (vs brisk in juvenile granulosa) • No luteinisation (frequent in juvenile granulosa)
• Some tubular structures: Sertoli? Sertoli-Leydig ?
• Some tubular structures: Sertoli? Extremely rare, all are small and entirely composed of tubules Sertoli-Leydig ? No Leydig cells!
• Branching and anastomosing tubules: • Looks like:
Tumors of the rete ovarii • Cystadenomas, papillary cystadenomas • Rete adenoma • Rete carcinoma • or maybe retiform Sertoli-Leydig Cell tumor
Rete adenoma • Growth patterns described are only tubular and papillary • No solid, no sieve-like patterns
• Looks sex-cord stromal • Looks like rete ovarii • With intraluminal thick eosinophilic secretions
Female adnexal tumor of probable wolffian origin (FATWO) – Most are described in the broad ligament, extremely rare in the ovary
Macroscopy • 14 x 11 x 10 cm mass • Encapsulated, bosselated, multinodular with solid cut surface • Attached to the broad ligament • Totally separated from the ovary (partially cystic, 6 x 4 x 2 cm)
Female Adnexal Tumor of probable Wolffian Origin (FATWO) • First described in 1973 by Kariminejad and Scully • Less 80 cases reported (17 to 83 yrs) • Most benign but ~ 10 cases malignant • All unilateral most often between the leaves of the broad ligament or attached to it or to the fallopian tube by a pedicle • Rare examples in the ovary (rete) and paravaginal
In favor of a wolffian origin • Their location: broad ligament, paratubal, ovary (rete) and paravaginal (where wolffian remnants are located) • Exclusion of other possibilities • Microscopic appearance compatible with such an origin • Compatible IHC (Hum Pathol 1999, 30: 856 -863 (25 cases); Histopathology 2001, 38: 237 -242 (6 cases))
Macroscopy • • 0. 5 -18 cm Cut surface solid or solid and cystic Gray-white to tan or yellow, firm or rubbery Hemorrhage and necrosis occasionally
Robboy’s 2009
Microscopy • Growth patterns: - Cystic or sieve-like (with eosinophilic secretions) - Tubular - Solid (sheets of cells or closely packed tubules) • Cells: - Epithelioid to fusiform - Pale to eosinophilic cytoplasm • Nuclei: - Round to oval with uniform chromatin - No or few mitotic figures
Immunohistochemistry Hum Pathol 1999, 30: 856 -863 • • • CK + (AE 1 -3 100%, Cam 5. 2 100%, CK 7 88%, HMW 17%) Vimentin + 100% EMA – (12%+) ER – (28% +), PR – (24% +), AR + 78% Inhibin 68% Calretinin 91% • IHC is supportive but not diagnostic • The diagnosis of FATWO is based on its morphological appearance
AE 1 -3 EMA Vimentin
Calretinin Inhibin ER PR
DDx • • • Granulosa cell tumor, adult-type Granulosa cell tumor, juvenile-type Sertoli-Leydig cell tumor Adenomatoid tumor Endometrioid carcinoma with FATWO-like patterns
Prognosis • Close to 10% have been clinically malignant (spread evident at time of surgery or recurrent disease) • Some were focally atypical but some were entirely bland: all FATWOs should be considered to have a malignant potential and the FU should be long term
Criteria for malignancy • Adverse outcome: – Capsular invasion +/- rupture with tumor implants – Large size (> 10 cm) – Hypercellularity • Worrysome: – Necrosis (often pedunculated) – High mitotic activity – Marked cellular atypia • Cannot tell: – Bland morphology, no/few mitotic activity
Treatment • TAH-BSO • Recurrent cases – No consensus for Tx – Poor response to chemo and radiation therapy – One case reported to be CD 117+ and responsive to Imatinib (no DNA sequencing done) – One case reported CD 117+ without mutation in exon 11 and 9, but no recurrent disease and not treated with Imatinib… – Possible role for hormonotherapy if ER+ and/or PR+ ?
Conclusion • FATWO is a rare tumor with a distinctive morphology • IHC is supportive but the Dx is based on morphology (and typical location) • If no clear cut malignancy: comment on the possible worrysome features and integrity of the capsule • Comment on the need for long term follow-up • Do IHC for CD 117, ER and PR
Merci!
Granulosa, adult-type? No Call-Exner No grooves!
Retiform SLCT • In favor: have retiform pattern and can also have sieve-like pattern BUT: • Retiform SLCT occur at a young age (mean 17 yrs) • Insular, lobulated growth pattern at low power • All are moderately or poorly differentiated SCLT with a component of loose fibrous or fibromyxoid mesenchymal stroma containing Leydig cells separating the epithelial nodules • Almost half of the Retiform variant have heterologous element
Adenomatoid tumor? • Too big (14 x 11 x 10 cm) • Too cellular and cells are too plump
• Numerous spaces of varying shape and size: Adenomatoid tumor?
Adenomatoid tumor? • Too big (14 x 11 x 10 cm) • Cells lining the cystic spaces are too plump